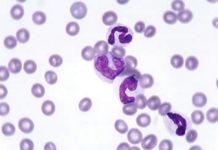
Ученые из Института Макса Планка изобрели новых медицинских микро-роботов

Глупо отрицать, что индустрия складных смартфонов на данный момент находится на довольно раннем этапе своего развития. И тем не менее, уже сейчас на рынке присутствуют компании, которые являются самыми успешными на данном поприще. Речь идёт, естественно, про южнокорейского технического гиганта Samsung. Прямо сейчас у компании имеется уже два складных устройства, а именно Galaxy Fold и Galaxy Z Flip, и это в любом случае больше, нежели у любого другого технического гиганта.
Но как бы то ни было, все мы с вами уже давно в курсе того, что сейчас Samsung занимается разработкой своего очередного складного телефона, который судя по слухам будет являться улучшенной во всех смыслах версией Galaxy Fold с приставкой «2». Однако факт разработки очередного, потенциально революционного устройства, не мешает столь крупной корпорации заниматься проектированием и других складных смартфонов. Всё дело в том, что на днях стало известно о том, что данная компания запатентовала очередную концепцию складного смартфона, и выглядит это крайне интересно и привлекательно.

Самым интересном в новоиспечённом патенте является то, что подобный смартфон может иметь ни одну, а сразу две линии сгиба – по одной сверху и снизу устройства. Подразумевается, что у людей будет возможность одновременно сложить нижнюю часть от себя, а верхнюю на себя. Однако если вы думаете, что телефон можно будет согнуть на пополам как в случае с упомянутым выше Galaxy Z Flip, то подобная возможность предусмотрена не будет – устройство не имеет механизма сгиба посередине. Так или иначе, отметить так же стоит и другой, крайне немаловажный факт, который заключается в том, что данный патент изначально был подан компанией Samsung ещё в 2018 году. И нет, не стоит рассчитывать, что в ближайшее время данный концепт будет реализован, ведь для этого корпорации необходимо разработать невероятно гибкий экран, который сможет гнуться в обе стороны.

Возможно данный смартфон и вовсе навсегда останется на стадии патента, так как с практической точки зрения данное устройство является попросту бесполезным. Если в случае с Galaxy Z Flip и Galaxy Fold возможность изгиба можно использовать в каких-никаких практических целях, то возможность сгиба смартфона таким образом, как изображено выше, является целиком и полностью бессмысленной и бесполезной. Так что вероятней всего на ближайшие годы компания решит сконцентрироваться на развитии, совершенствовании и популяризации гибких телефонов на подобии уже упомянутых Galaxy Z Flip и Galaxy Fold, ведь именно они имеют наиболее высокие шансы стать массовыми и популярными продуктами, чьим особенностям можно найти практическое применение.